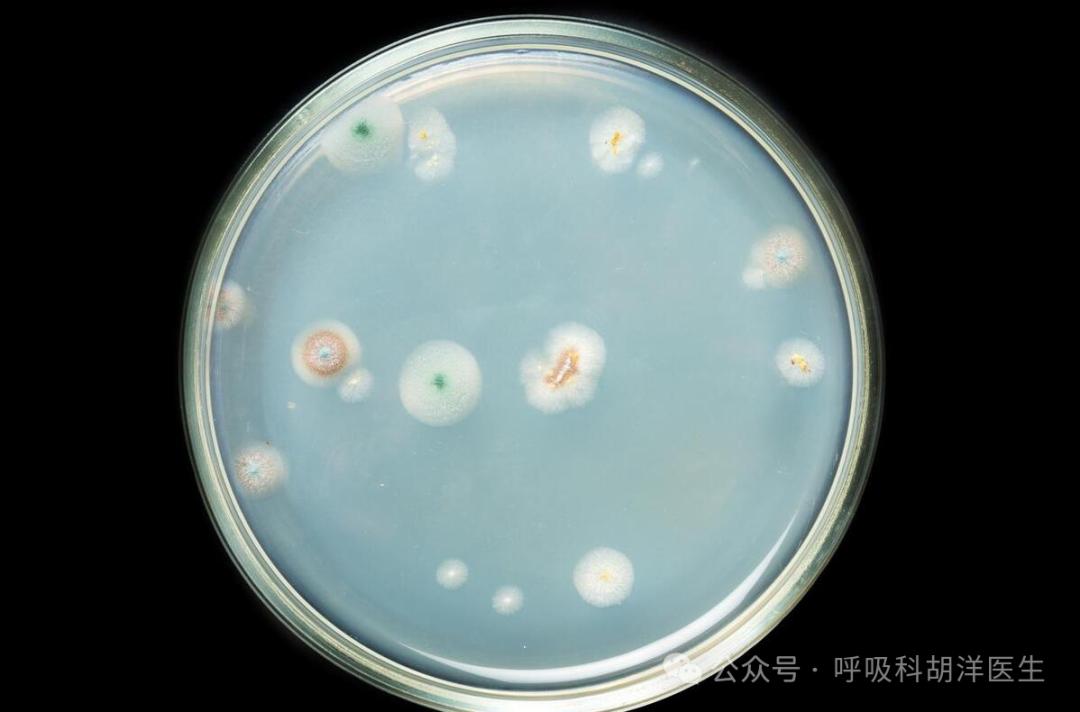

- +1
抗生素的发展史从治疗梅毒开始,目前最大的隐忧是细菌“成精”
原创 胡洋大夫
我们日常所说的消炎药,其实并没有消炎作用,真身是抗生素,主要是杀灭病原体的,因为病原体杀灭了,炎症也就好了,所以老百姓习惯性的成为消炎药,其实消炎药分两种,一种是糖皮质激素,一种是非甾体抗炎药,可以抑制炎症细胞赶往“案发现场”,所以称为消炎药。
说远了,抗生素可以说是临床上最常用的药物了,也是现代药学发展的基石,抗生素的问世让人类大大摆脱了病原体的威胁,深度改变了人类疾病谱,高度延长了整体预期寿命,人类数量从此进入了大爆炸时代。这么伟大的发明,很多人不知道是从治疗梅毒开始发端的。
人们总是记得重大的历史事件,抗生素真正大放异彩的代表是二战期间青霉素,它拯救了大量盟军士兵的生命,甚至是二战盟军取胜的一个重要因素,青霉素无疑是抗生素当中的始皇帝,但其实青霉素并非人类历史上首个抗生素,治疗梅毒的药物才是人类历史上第一个抗生素。
 梅毒15世纪在法国军队中爆发,随后迅速肆虐整个欧洲,当时科技不发达,大家并没有意识到这是一种有病原体相互感染导致的传染病,这个现在很容易治愈的疾病,在当时甚至是一个致残乃至致死的疾病,由于发病机理不明确,因此治疗上也是五花八门,开始用水银治疗,随后还发明了各占各样的有毒金属熏蒸的治疗方法,有些人在治疗梅毒的过程中金属中毒而死,感染者非常的痛苦。
梅毒15世纪在法国军队中爆发,随后迅速肆虐整个欧洲,当时科技不发达,大家并没有意识到这是一种有病原体相互感染导致的传染病,这个现在很容易治愈的疾病,在当时甚至是一个致残乃至致死的疾病,由于发病机理不明确,因此治疗上也是五花八门,开始用水银治疗,随后还发明了各占各样的有毒金属熏蒸的治疗方法,有些人在治疗梅毒的过程中金属中毒而死,感染者非常的痛苦。直到1905年,人们才第一次分离并鉴定出引起梅毒的病原体-梅毒螺旋体,德国科学家保罗·埃尔利希随后展开了研究,他的助手秦佐八郎发现“六〇六”号试剂(砷凡纳明)能使感染梅毒的兔子康复,经过临床验证,该药能有效治疗梅毒,而且副作用较小,这是人类历史上第一个抗生素,在青霉素问世之前,该药一直是治疗梅毒最好的药物。
1912年,溶解性更好,更易操作,但疗效稍差的新胂凡钠明(同为化合物,914)上市。洒尔佛散和914几十年来都保持着治疗梅毒重磅药物的地位,直到 20世纪40年代抗生素问世。
 保罗·埃尔利希是多学科天才,是化学、免疫学以及药物学等多个学科的奠基人之一,1908年,他由于对免疫学的杰出贡献而获得诺贝尔生理医奖。
保罗·埃尔利希是多学科天才,是化学、免疫学以及药物学等多个学科的奠基人之一,1908年,他由于对免疫学的杰出贡献而获得诺贝尔生理医奖。那为什么说青霉素是抗生素界的“始皇帝”呢?
其实青霉素并非一问世就那么耀眼夺目的,它是在一个非常偶然事件中被发现的,英国科学家亚历山大·弗莱明将一个落了灰尘的培养基扔在了一边,本想遗弃掉它,但仔细观察后赫然发现,落了灰尘的地方长出了霉斑,而霉斑的周围形成了一个“无菌环”,这个一现象引起了他的注意,为什么霉斑周围细菌不能靠近呢?虽然没有研究出其中到底什么成分杀灭了细菌,但他把霉斑里的微生物保留了下来,直到1939年,弗莱明毫不犹豫地把菌种提供给了澳大利亚病理学家弗洛里和生物化学家钱恩。经过一年多时间的尝试,最终于1940年分离纯化出了青霉素,而其化学结构直到1945年才被确定。1942年开始大批量生产青霉素,并用于临床,这才有效地抑制了细菌疾病的疯狂蔓延,拯救了无数人的生命。
青霉素的问世大大刺激了抗生素的发展,此后数十年,无数研究人员投入到抗生素的开发中,磺胺类、大环内酯类、氨基糖苷类以及氟喹诺酮类抗生素先后问世,微生物的肆虐得到了大大的压制,以前被视为绝症的感染,逐渐得到控制,甚至像肺结核这样曾经导致无数人死亡的疾病,都被攻克。
青霉素的问世大大刺激了抗生素的发展,此后数十年,无数研究人员投入到抗生素的开发中,磺胺类、大环内酯类、氨基糖苷类以及氟喹诺酮类抗生素先后问世,微生物的肆虐得到了大大的压制,以前被视为绝症的感染,逐渐得到控制,甚至像肺结核这样曾经导致无数人死亡的疾病,都被攻克。细菌耐药问题开始反噬人类。
即使是抗生素有如此多的种类可供选择,多数抗生素仍然发挥着强大抗菌活性的今天,下呼吸道感染性疾病仍然高居导致人类死亡排行榜第四位,如果把各个系统感染致死的人数加起来,这个排名至少要向前多排两三位,导致这种问题的一个重要原因是细菌耐药,《The Lancet》最新发表的“2019年全球抗细菌药物耐药负担系统分析”:抗生素耐药是当前全球主要死因,超过了许多公认的死亡原因;2019年约127万人直接死于抗生素耐药,495万人的死亡与抗生素耐药相关;全球迫切需要解决抗生素的耐药问题。
 细菌耐药的机制处处体现着细菌的精明,如果你充分了解了其中道理,你甚至会认为细菌都“成精”了,细菌会采取哪些方法导致药物失去作用呢,第一是外排,有些抗生素需要进入到细菌内部起作用,细菌可以采取方法把这些抗生素排出去,第二是吸收降低,有些细菌会在外表面形成被膜,抗生素就无法进入到细菌内部起作用了,第三是质粒介导的耐药,这种方式可以在细菌个体之间传递耐药基因,从而使未接触过抗生素的细菌直接获得耐受抗生素的能力,第四是改变基因,基因突变是药物失去进攻的靶点,药物就会失去作用了。
细菌耐药的机制处处体现着细菌的精明,如果你充分了解了其中道理,你甚至会认为细菌都“成精”了,细菌会采取哪些方法导致药物失去作用呢,第一是外排,有些抗生素需要进入到细菌内部起作用,细菌可以采取方法把这些抗生素排出去,第二是吸收降低,有些细菌会在外表面形成被膜,抗生素就无法进入到细菌内部起作用了,第三是质粒介导的耐药,这种方式可以在细菌个体之间传递耐药基因,从而使未接触过抗生素的细菌直接获得耐受抗生素的能力,第四是改变基因,基因突变是药物失去进攻的靶点,药物就会失去作用了。 抗生素的开发速度和细菌耐药速度之间是相互竞争关系,目前开发速度甚至赶不上细菌耐药的速度,有些超级细菌对现在所有的抗生素都不敏感,感染上之后只能眼看着病情逐渐加重,最后失去生命,这不得不让人感到担忧。
抗生素的开发速度和细菌耐药速度之间是相互竞争关系,目前开发速度甚至赶不上细菌耐药的速度,有些超级细菌对现在所有的抗生素都不敏感,感染上之后只能眼看着病情逐渐加重,最后失去生命,这不得不让人感到担忧。本文为澎湃号作者或机构在澎湃新闻上传并发布,仅代表该作者或机构观点,不代表澎湃新闻的观点或立场,澎湃新闻仅提供信息发布平台。申请澎湃号请用电脑访问http://renzheng.thepaper.cn。





- 报料热线: 021-962866
- 报料邮箱: news@thepaper.cn
互联网新闻信息服务许可证:31120170006
增值电信业务经营许可证:沪B2-2017116
© 2014-2026 上海东方报业有限公司




